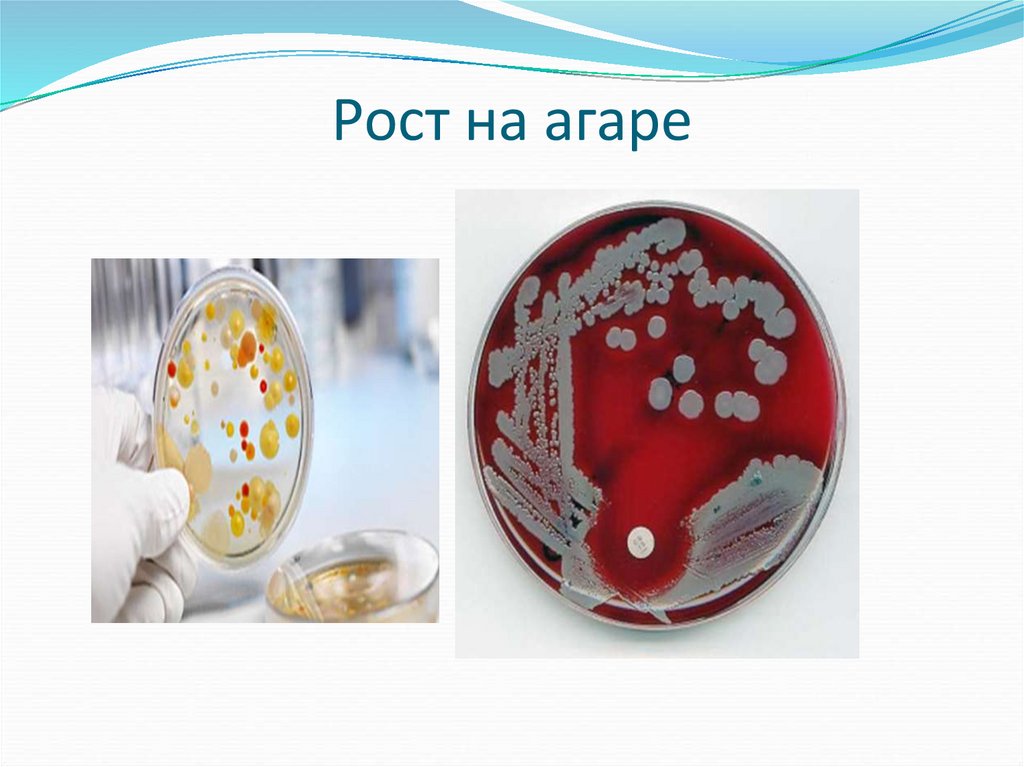
Рост на агаре

Similar presentations:
Физиология микроорганизмов
1.
2. ПЛАН ЛЕКЦИИ
1. Питание бактерий.2. Дыхание бактерий.
3. Рост и размножение бактерий.
4. Методы стерилизации
3.
4.
Питание - этопоступление внутрь
бактерий веществ и их
усвоение
5. Процесс питания имеет ряд особенностей:
поступление питательных веществосуществляется через всю поверхность
клетки;
микробная клетка имеет исключительную
скорость метаболических реакций;
микроорганизмы способны быстро
адаптироваться к условиям среды, в которой
находятся.
6. Тип питания бактерий:
голофиты – утилизируютпитательные вещества, которые
находятся в растворенном виде;
голозои – утилизируют
твердофазные объекты с помощью
внешнего питания
7. По источнику углерода:
Автотрофы –используют в качествеисточника углерода только углекислый
газ;
Гетеротрофы – берут углерод из
органических соединений;
Гипотрофы – обеспечивают себя
углеродом, реорганизуя клеточные
структуры или метаболиты хозяина
8.
9. По источнику азота
аминоавтотрофы – используютатмосферный или минеральный
азот;
аминогетеротрофы – способны
утилизировать азот только из
органических веществ.
10. Питание бактерий
1. Осмос и диффузия (пассивнаядиффузия) - по градиенту концентраций.
Без затраты энергии;
2. Облегченная диффузия - по градиенту
концентрации, без затраты энергии, с
помощью белков-переносчиков;
3. Активный транспорт (против
градиента концентрации, с затратой
энергии).
11.
12.
13. Классы Ферментов
1. Оксидоредуктазы.2. Трансферразы.
3. Гидролазы.
4. Лиазы.
5. Изомеразы.
6. Лигазы или синтетазы.
14.
1. Конститутивные - постоянносинтезируются в микробных клетках в
определенных .
2. Индуцибельные - их концентрация
резко возрастает в зависимости от
наличия соответствующего субстрата.
3. Репрессибельные - ферменты, синтез
которых блокируется конечными
продуктами.
15. Питательные среды
По назначениюУниверсальные (МПБ- мясная вода, 1% пептон, 0,5%
натрия хлорид; МПА –МПБ И 2-3% агара);
Дифференциально-диагностические(среды: Эндо,
Плоскирева, пестрый ряд Гисса, Ресселя и др.);
Селективные( избирательные,элективные,
обогатительные). Среды: Раппопорт, ЖСА, 1%
пептонная вода;
Специальные( кровяной агар, среда ЛевенштейнаЙенсена
16. Питательные среды
По происхождению:1. Естественные.
2. Искусственные:
синтетические;
полусинтетические
17. 2. Дыхание бактерий
Дыхание – переносэлектронов с донора на
акцептор, в результате чего
образуется макроэргическое
соединение
18.
19. По донору электронов:
1) Литотрофы(донорыэлетронов - неорганические
соединения;
2) Органотрофы(доноры
электронов – органические
соединения).
20. По акцептору электронов
1) Аэробы(акцептор электронов –молекулярный кислород);
2) Анаэробы(акцептор электронов –
неорганические соединения);
3) Факультативные анаэробы(могут
расти и размножаться как в
присутствии кислорода, так и без него);
4) Микроаэрофилы .
21.
22.
23.
24.
25. 3.Рост и размножение бактерий
Рост – координированноевоспроизведение всех клеточных
компонентов и структур,
ведущее к увеличению массы
клетки.
Размножение – это увеличение
числа клеток в популяции.
26.
27.
28.
29.
30. Рост на жидких питательных средах
31. Рост на агаре
32. Рост на скошенном агаре
33.
34.
35. 4. Методы стерилизации
Стерилизация – полноеосвобождение различных
веществ и предметов от
микроорганизмов и их
спор.
36. Методы стерилизации
1. Механические( фильтрация,центрифугирование).
2. Физические (кипячение, прокаливание,
автоклавирование, воздействие УФО и
гамма-лучами).
3. Химические ( использование
дезенфицирующих средств).
37.
Благодарю завнимание!

biology
biology








